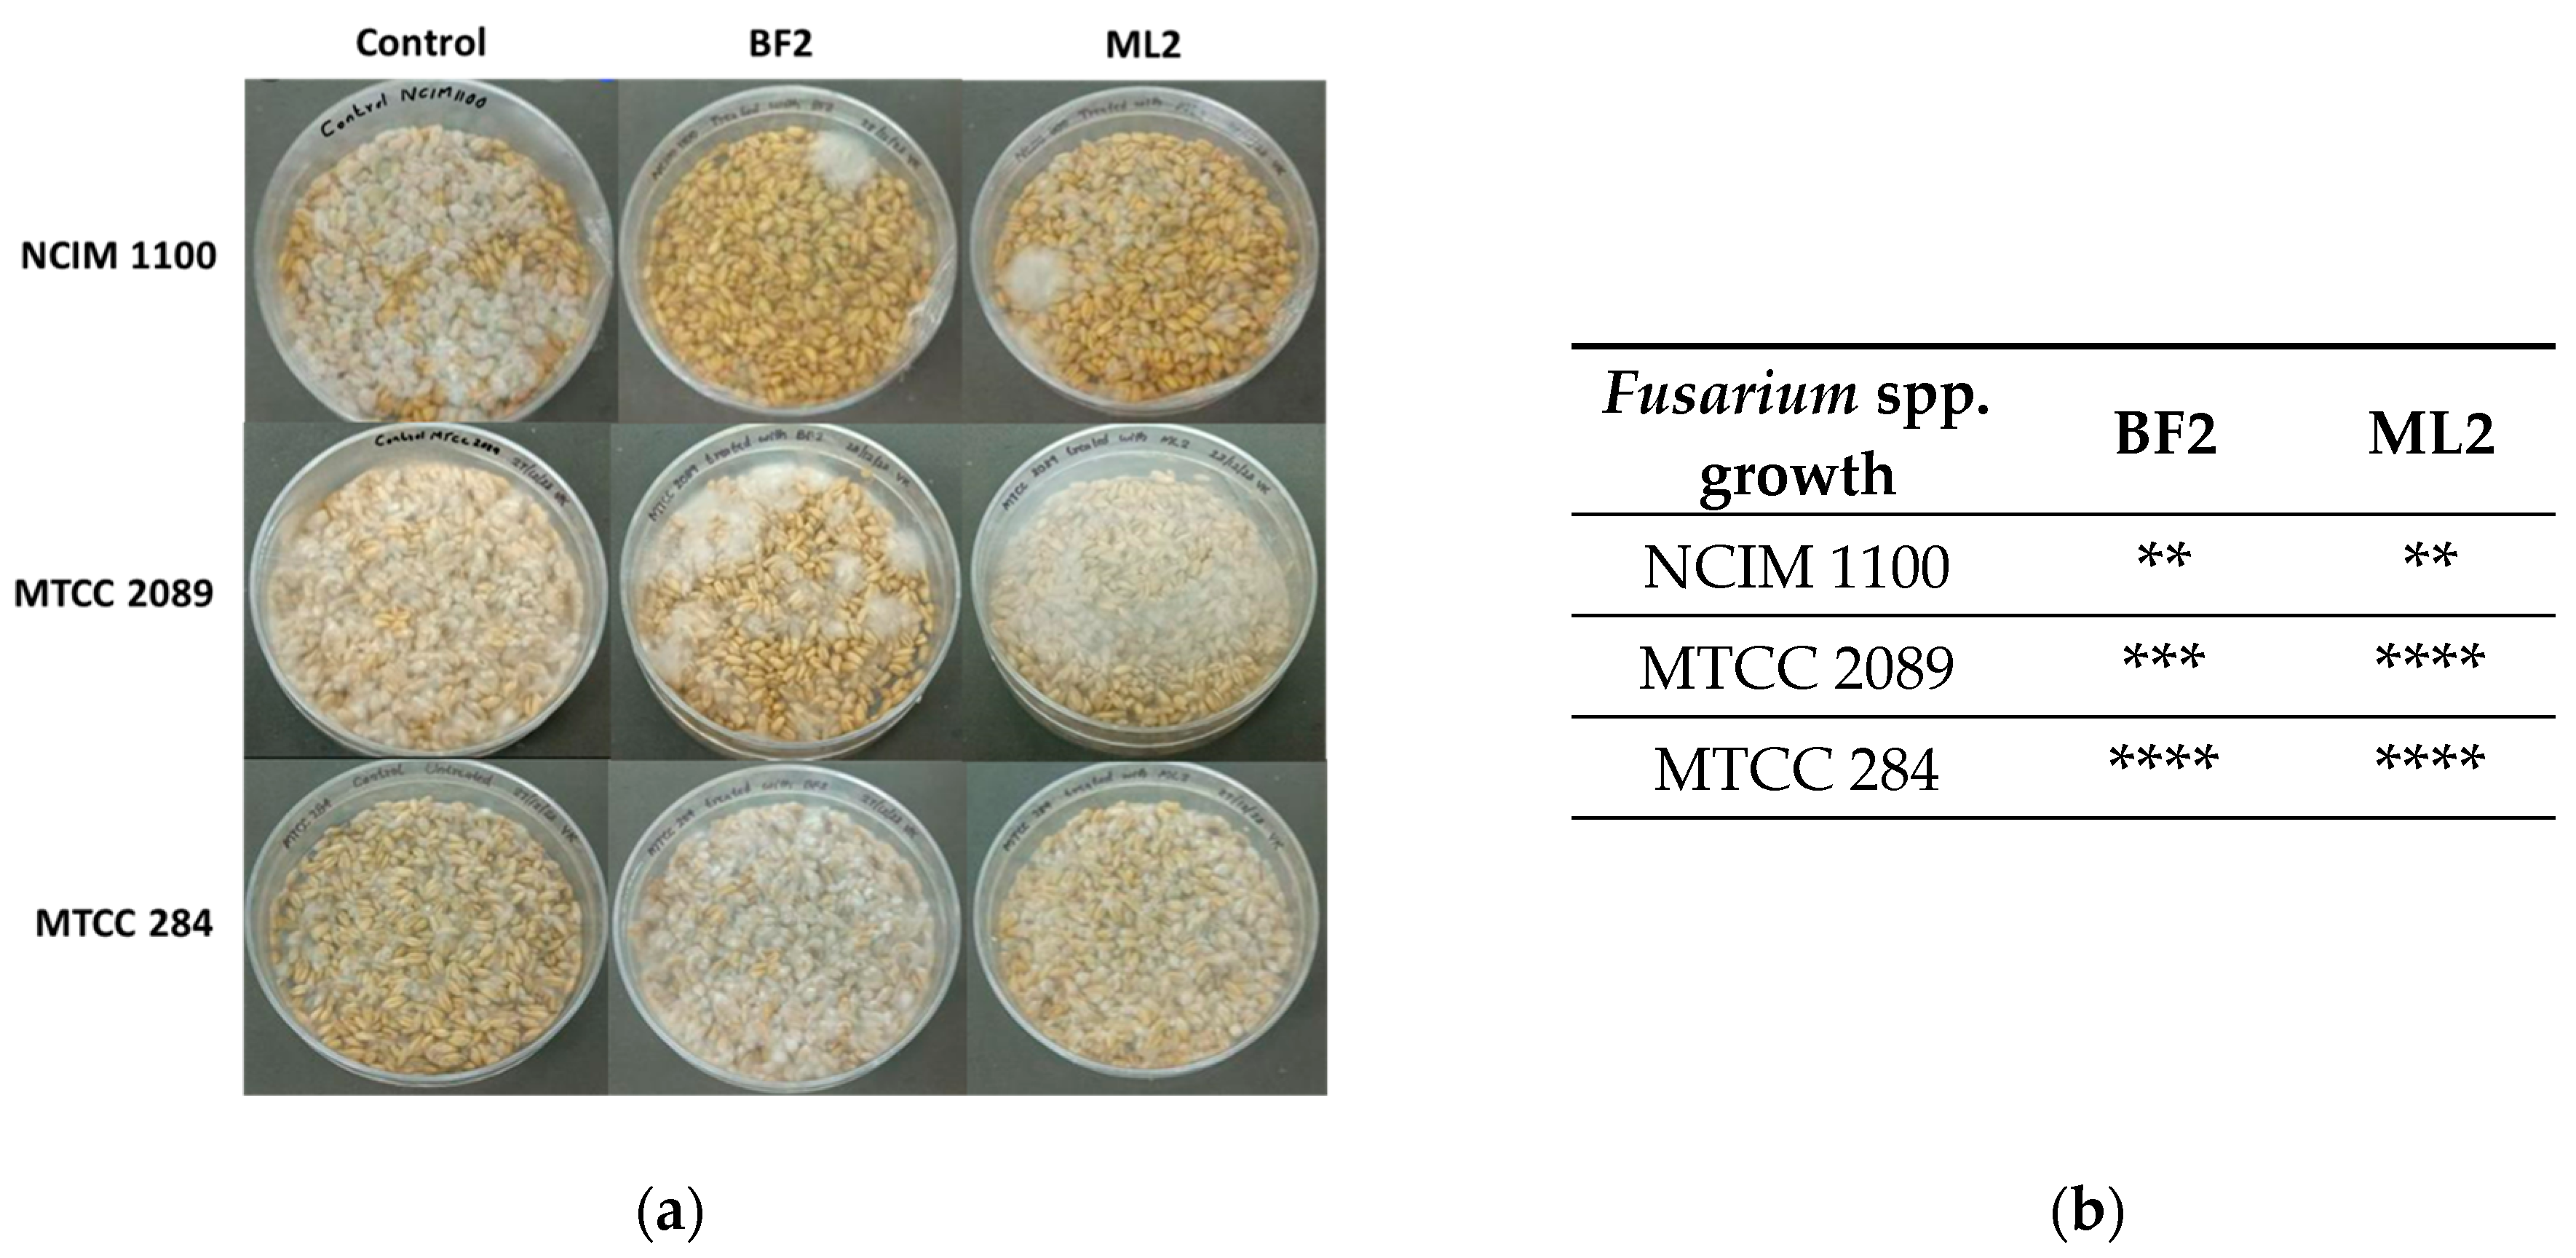
Microorganisms 13 00666 g006

Unveiling the Perspective on Weissella confusa as a Promising Biocontrol Agent Against Fusaria
Abstract
1. Introduction
2. Materials and Methods
2.1. Microorganisms
2.2. Characterization of the Bacteria
2.3. Antagonism Test
2.4. Preparation of Bioactive Extracts and Well Diffusion Assay
2.5. Mycotoxin Detection with HPLC Method
2.6. Mycotoxin Detection with ELISA Method
2.7. Mycotoxin Resistance Tests
2.8. Mycotoxin Reduction Tests
2.9. Biocontrol Efficacy of CFCS on Grains
2.10. Statistical Analyses
3. Results
3.1. Characterization of Bacterial Isolates
3.2. Fusarium Antagonism
3.3. Mycotoxin Resistance and Reduction
3.4. Biocontrol Tests
4. Discussion
Author Contributions
Funding
Institutional Review Board Statement
Informed Consent Statement
Data Availability Statement
Conflicts of Interest
Abbreviations
| CFCS | Cell-Free Culture Supernatant |
| DON | Deoxynivalenol |
| ZEA | Zearalenone |
| FB1 | Fumonisin B1 |
| FDA | U.S. Food and Drug Administration |
| EFSA | European Food Safety Authority |
| LAB | Lactic Acid Bacterium |
| PDA | Potato Dextrose Agar |
| PDB | Potato Dextrose Broth |
| MRS | de-Man-Rogosa-Sharpe |
| MHA | Mueller- Hinton Agar |
| NCIM | National Collection of Industrial Microorganisms |
| ATCC | American Type Culture Collection |
| MTCC | Microbial Type Culture Collection and Gene Bank |
| EA | ethyl acetate |
References
- Collins, M.D.; Samelis, J.; Metaxopoulos, J.; Wallbanks, S. Taxonomic studies on some leuconostoc-like organisms from fermented sausages: Description of a new genus Weissella for the Leuconostoc paramesenteroides group of species. J. Appl. Bacteriol. 1993, 75, 595–603. [Google Scholar] [CrossRef]
- Sharpe, M.E.; Garvie, E.I.; Tilbury, R.H. Some slime-forming heterofermentative species of the genus Lactobacillus. Appl. Microbiol. 1972, 23, 389–397. [Google Scholar] [CrossRef]
- Holzapfel, W.H.; Kandler, O. Zur Taxonomie der Gattung Lactobacillus Beijerinck. VI. Lactobacillus coprophilus subsp. confusus nov. subsp., eine neue Unterart der Untergattung Betabacterium [Taxonomy of the species Lactobacillus Beijerinck. VI. Lactobacillus coprophilus subsp. confusus nov. subsp., a new variety of the subspecies Betabacterium]. Zentralbl. Bakteriol. Parasitenkd. Infektionskr. Hyg. 1969, 123, 657–666. (In German) [Google Scholar] [PubMed]
- Björkroth, J.; Dicks, L.M.; Endo, A. The genus Weissella. In Lactic Acid Bacteria: Biodiversity and Taxonomy; Holzapfel, W.H., Wood, B.J.B., Eds.; Wiley-Blackwell: Hoboken, NJ, USA, 2014; pp. 417–428. [Google Scholar] [CrossRef]
- Fusco, V.; Quero, G.M.; Cho, G.S.; Kabisch, J.; Meske, D.; Neve, H.; Bockelmann, W.; Franz, C.M.A.P. The genus Weissella: Taxonomy, ecology and biotechnological potential. Front. Microbiol. 2015, 6, 155. [Google Scholar] [CrossRef]
- Kavitake, D.; Singh, S.P.; Kandasamy, S.; Devi, P.B.; Shetty, P.H. Report on aflatoxin-binding activity of galactan exopolysaccharide produced by Weissella confusa KR780676. 3 Biotech 2020, 10, 181. [Google Scholar] [CrossRef] [PubMed]
- Yeu, J.E.; Lee, H.G.; Park, G.Y.; Lee, J.; Kang, M.S. Antimicrobial and antibiofilm activities of Weissella cibaria against pathogens of upper respiratory tract infections. Microorganisms 2021, 9, 1181. [Google Scholar] [CrossRef]
- Kariyawasam, K.M.G.M.M.; Jeewanthi, R.K.C.; Lee, N.K.; Paik, H.D. Characterization of cottage cheese using Weissella cibaria D30: Physicochemical, antioxidant, and antilisterial properties. J. Dairy Sci. 2019, 102, 3887–3893. [Google Scholar] [CrossRef] [PubMed]
- Nam, H.; Ha, M.; Bae, O.; Lee, Y. Effect of Weissella confusa strain PL9001 on the adherence and growth of Helicobacter pylori. Appl. Environ. Microbiol. 2002, 68, 4642–4645. [Google Scholar] [CrossRef]
- Dey, D.K.; Khan, I.; Kang, S.C. Anti-bacterial susceptibility profiling of Weissella confusa DD_A7 against the multidrug-resistant ESBL-positive E. coli. Microbial. Pathogen. 2019, 128, 119–130. [Google Scholar] [CrossRef]
- Singh, J.K.; Devi, P.B.; Reddy, G.B.; Jaiswal, A.K.; Kavitake, D.; Shetty, P.H. Biosynthesis, classification, properties, and applications of Weissella bacteriocins. Front. Microbiol. 2024, 15, 1406904. [Google Scholar] [CrossRef]
- Fessard, A.; Remize, F. Why are Weissella spp. not used as commercial starter cultures for food fermentation? Fermentation 2017, 3, 38. [Google Scholar] [CrossRef]
- Cupi, D.; Elvig-Jørgensen, S.G. Safety assessment of Weissella confuse—A direct-fed microbial candidate. Reg. Toxicol. Pharmacol. 2019, 107, 104414. [Google Scholar] [CrossRef] [PubMed]
- Kang, M.S.; Yeu, J.E.; Hong, S.P. Safety evaluation of oral care probiotics Weissella cibaria CMU and CMS1 by phenotypic and genotypic analysis. Int. J. Mol. Sci. 2019, 20, 2693. [Google Scholar] [CrossRef]
- Bourdichon, F.; Patrone, V.; Fontana, A.; Milani, G.; Morelli, L. Safety demonstration of a microbial species for use in the food chain: Weissella confusa. Int. J. Food Microbiol. 2021, 339, 109028. [Google Scholar] [CrossRef]
- Oliveira, P.M.; Zannini, E.; Arendt, E.K. Cereal fungal infection, mycotoxins, and lactic acid bacteria mediated bioprotection: From crop farming to cereal products. Food Microbiol. 2014, 37, 78–95. [Google Scholar] [CrossRef]
- Gonçalves, A.; Gkrillas, A.; Dorne, J.L.; Dall’Asta, C.; Palumbo, R.; Lima, N.; Battilani, P.; Venâncio, A.; Giorni, P. Pre-and postharvest strategies to minimize mycotoxin contamination in the rice food chain. Comp. Rev. Food Sci. Food Safety 2019, 18, 441–454. [Google Scholar] [CrossRef]
- Muhialdin, B.J.; Saari, N.; Meor Hussin, A.S. Review on the biological detoxification of mycotoxins using lactic acid bacteria to enhance the sustainability of foods supply. Molecules 2020, 25, 2655. [Google Scholar] [CrossRef]
- Byrne, M.B.; Thapa, G.; Doohan, F.M.; Burke, J.I. Lactic acid bacteria as potential biocontrol agents for Fusarium head blight disease of spring barley. Front. Microbiol. 2022, 13, 912632. [Google Scholar] [CrossRef] [PubMed]
- Mateo, E.M.; Tarazona, A.; Jiménez, M.; Mateo, F. Lactic acid bacteria as potential agents for biocontrol of aflatoxigenic and ochratoxigenic fungi. Toxins 2022, 14, 807. [Google Scholar] [CrossRef]
- Nasrollahzadeh, A.; Mokhtari, S.; Khomeiri, M.; Saris, P. Mycotoxin detoxification of food by lactic acid bacteria. Intern. J. Food Cont. 2022, 9, 1. [Google Scholar] [CrossRef]
- Hirozawa, M.T.; Ono, M.A.; Suguiura, I.M.D.S.; Bordini, J.G.; Ono, E.Y.S. Lactic acid bacteria and Bacillus spp. as fungal biological control agents. J. Appl. Microbiol. 2023, 134, lxac083. [Google Scholar] [CrossRef] [PubMed]
- Azevedo, I.; Barbosa, J.; Albano, H.; Nogueira, T.; Teixeira, P. Lactic Acid Bacteria isolated from traditional and innovative alheiras as potential biocontrol agents. Food Microbiol. 2024, 119, 104450. [Google Scholar] [CrossRef]
- Munkvold, G.P. Fusarium Species and Their Associated Mycotoxins. In Mycotoxigenic Fungi. Methods in Molecular Biology; Moretti, A., Susca, A., Eds.; Humana Press: New York, NY, USA, 2017; Volume 1542. [Google Scholar] [CrossRef]
- Krishnan, S.V.; Nampoothiri, K.M.; Suresh, A.; Linh, N.T.; Balakumaran, P.A.; Pócsi, I.; Pusztahelyi, T. Fusarium biocontrol: Antagonism and mycotoxin elimination by lactic acid bacteria. Front. Microbiol. 2024, 14, 1260166. [Google Scholar] [CrossRef] [PubMed]
- Kamle, M.; Mahato, D.K.; Devi, S.; Lee, K.E.; Kang, S.G.; Kumar, P. Fumonisins: Impact on agriculture, food, and human health and their management strategies. Toxins 2019, 11, 328. [Google Scholar] [CrossRef] [PubMed]
- Blacutt, A.A.; Gold, S.E.; Voss, K.A.; Gao, M.; Glenn, A.E. Fusarium verticillioides: Advancements in understanding the toxicity, virulence, and niche adaptations of a model mycotoxigenic pathogen of maize. Phytopathology 2018, 108, 312–326. [Google Scholar] [CrossRef]
- Hao, G.; McCormick, S.; Usgaard, T.; Tiley, H.; Vaughan, M.M. Characterization of three Fusarium graminearum effectors and their roles during Fusarium head blight. Front. Plant Sci. 2020, 11, 579553. [Google Scholar] [CrossRef]
- Mirocha, C.J.; Abbas, H.K.; Kommedahl, T.; Jarvis, B.B. Mycotoxin production by Fusarium oxysporum and Fusarium sporotrichioides isolated from Baccharis spp. from Brazil. Appl. Environ. Microbiol. 1989, 55, 254–255. [Google Scholar] [CrossRef]
- López-Berges, M.S.; Hera, C.; Sulyok, M.; Schäfer, K.; Capilla, J.; Guarro, J.; Di Pietro, A. The velvet complex governs mycotoxin production and virulence of Fusarium oxysporum on plant and mammalian hosts. Mol. Microbiol. 2013, 87, 49–65. [Google Scholar] [CrossRef]
- Cheli, F.; Campagnoli, A.; Dell’Orto, V. Fungal populations and mycotoxins in silages: From occurrence to analysis. Anim. Feed Sci. Technol. 2013, 183, 1–16. [Google Scholar] [CrossRef]
- Wang, Z.; Jia, S.; Xue, Y.; Wu, W.; Zhao, Y.; Li, Y.; Lv, H. Weissella cibaria DA2 cell-free supernatant improves the quality of sweet corn kernels during post-harvest storage. Postharvest Biol. Technol. 2024, 215, 113021. [Google Scholar] [CrossRef]
- Yun, J.; Kim, T.W.; Cho, C.W.; Lee, J.E. Antifungal mechanisms investigation of lactic acid bacteria against Aspergillus flavus: Through combining microbial metabolomics and co-culture system. J. Appl. Microbiol. 2024, 135, lxae112. [Google Scholar] [CrossRef]
- Bata-Vidács, I.; Kosztik, J.; Mörtl, M.; Székács, A.; Kukolya, J. Aflatoxin B1 and sterigmatocystin binding potential of non-Lactobacillus LAB strains. Toxins 2020, 12, 799. [Google Scholar] [CrossRef]
- Lowe, D.P.; Ulmer, H.M.; Graser, K.; Arendt, E.K. The influence of starter cultures on barley contaminated with Fusarium culmorum TMW 4.0754. J. Am. Soc. Brew. Chem. 2006, 64, 158–165. [Google Scholar] [CrossRef]
- Krishnan, S.V.; Anaswara, P.A.; Nampoothiri, K.M.; Kovács, S.; Adácsi, C.; Szarvas, P.; Király, S.; Pócsi, I.; Pusztahelyi, T. Biocontrol activity of new lactic acid bacteria isolates against Fusaria and Fusarium mycotoxins. Toxins 2025, 17, 68. [Google Scholar] [CrossRef] [PubMed]
- Benson, D.A.; Cavanaugh, M.; Clark, K.; Karsch-Mizrachi, I.; Lipman, D.J.; Ostell, J.; Sayers, E.W. GenBank. Nucleic Acids Res. 2013, 41, D36–D42. [Google Scholar] [CrossRef]
- Adácsi, C.; Kovács, S.; Pócsi, I.; Győri, Z.; Dombrádi, Z.; Pusztahelyi, T. Microbiological and toxicological evaluation of fer-mented forages. Agriculture 2022, 12, 421. [Google Scholar] [CrossRef]
- Poornachandra Rao, K.; Chennappa, G.; Suraj, U.; Nagaraja, H.; Charith Raj, A.P.; Sreenivasa, M.Y. Probiotic potential of Lactobacillus strains isolated from sorghum-based traditional fermented food. Probiot. Antimicrob. Prot. 2015, 7, 146–156. [Google Scholar] [CrossRef]
- Husain, A.; Hassan, Z.; Huda-Faujan, N.; Lani, M.N. Antifungal activity of lactic acid bacteria isolated from soil rhizosphere on Fusarium species infected chilli seeds. Am. Sci. Res. J. Eng. Technol. Sci. 2017, 29, 182–202. [Google Scholar]
- Rouse, S.; Harnett, D.; Vaughan, A.; Sinderen, D.V. Lactic acid bacteria with potential to eliminate fungal spoilage in foods. J. Appl. Microbiol. 2008, 104, 915–923. [Google Scholar] [CrossRef]
- Valerio, F.; Favilla, M.; De Bellis, P.; Sisto, A.; de Candia, S.; Lavermicocca, P. Antifungal activity of strains of lactic acid bacteria isolated from a semolina ecosystem against Penicillium roqueforti, Aspergillus niger and Endomyces fibuliger contaminating bakery products. Syst. Appl. Microbiol. 2009, 32, 438–448. [Google Scholar] [CrossRef]
- Bangar, S.P.; Chaudhary, V.; Singh, T.P.; Özogul, F. Retrospecting the concept and industrial significance of LAB bacteriocins. Food Biosci. 2022, 46, 101607. [Google Scholar] [CrossRef]
- Salman, M.; Javed, M.R.; Ali, H.; Mustafa, G.; Tariq, A.; Sahar, T.; Naheed, S.; Gill, I.; Abid, M.; Tawab, A. Bioprotection of Zea mays L. from aflatoxigenic Aspergillus flavus by Loigolactobacillus coryniformis BCH-4. PLoS ONE 2022, 17, e0271269. [Google Scholar] [CrossRef]
- Dalié, D.K.D.; Deschamps, A.M.; Richard-Forget, F. Lactic acid bacteria–Potential for control of mould growth and mycotoxins: A review. Food Control 2010, 21, 370–380. [Google Scholar] [CrossRef]
- Belal, J.M.; Zaiton, H.; Kh, S.S.; Aqilah, Z.N.; Azfar, A.A. Effect of pH and heat treatment on antifungal activity of Lactobacillus fermentum Te007, Lactobacillus pentosus G004 and Pediococcus pentosaceus Te010. Inn. Romanian Food Biotech. 2011, 8, 41–53. [Google Scholar]
- Laitila, A.; Alakomi, H.L.; Raaska, L.; Mattila-Sandholm, T.; Haikara, A. Antifungal activities of two Lactobacillus plantarum strains against Fusarium moulds in vitro and in malting of barley. J. Appl. Microbiol. 2002, 93, 566–576. [Google Scholar] [CrossRef] [PubMed]
- Ndagano, D.; Lamoureux, T.; Dortu, C.; Vandermoten, S.; Thonart, P. Antifungal activity of 2 lactic acid bacteria of the Weissella genus isolated from food. J. Food Sci. 2011, 76, M305–M311. [Google Scholar] [CrossRef] [PubMed]
- Goh, H.F.; Philip, K. Purification and characterization of bacteriocin produced by Weissella confusa A3 of dairy origin. PLoS ONE 2015, 10, e0140434. [Google Scholar] [CrossRef]
- Quattrini, M.; Korcari, D.; Ricci, G.; Fortina, M.G. A polyphasic approach to characterise Weissella cibaria and Weissella confusa strains. J. Appl. Microbiol. 2020, 128, 500–512. [Google Scholar] [CrossRef]
- Somashekaraiah, R.; Mottawea, W.; Gunduraj, A.; Joshi, U.; Hammami, R.; Sreenivasa, M.Y. Probiotic and antifungal attributes of Levilactobacillus brevis MYSN105, isolated from an Indian traditional fermented food Pozha. Front. Microbiol. 2021, 12, 696267. [Google Scholar] [CrossRef]

| LAB Strain | Source | Gram Staining | Catalase Assay | MRS+ CaCO3 | Accession Number * | |
|---|---|---|---|---|---|---|
| BF2 | Weissella confusa | Newborn feces | + | - | + | PP029339 |
| ML2 | Weissella confusa | Cow milk | + | - | + | PP535080 |
Disclaimer/Publisher’s Note: The statements, opinions and data contained in all publications are solely those of the individual author(s) and contributor(s) and not of MDPI and/or the editor(s). MDPI and/or the editor(s) disclaim responsibility for any injury to people or property resulting from any ideas, methods, instructions or products referred to in the content. |
© 2025 by the authors. Licensee MDPI, Basel, Switzerland. This article is an open access article distributed under the terms and conditions of the Creative Commons Attribution (CC BY) license (https://creativecommons.org/licenses/by/4.0/).
Share and Cite
Krishnan, S.V.; Anaswara, P.A.; Nampoothiri, K.M.; Kovács, S.; Adácsi, C.; Miklós, I.; Király, S.; Pócsi, I.; Pusztahelyi, T. Unveiling the Perspective on Weissella confusa as a Promising Biocontrol Agent Against Fusaria. Microorganisms 2025, 13, 666. https://doi.org/10.3390/microorganisms13030666
Krishnan SV, Anaswara PA, Nampoothiri KM, Kovács S, Adácsi C, Miklós I, Király S, Pócsi I, Pusztahelyi T. Unveiling the Perspective on Weissella confusa as a Promising Biocontrol Agent Against Fusaria. Microorganisms. 2025; 13(3):666. https://doi.org/10.3390/microorganisms13030666
Chicago/Turabian StyleKrishnan, Sukumaran Vipin, Prakasan A. Anaswara, Kesavan Madhavan Nampoothiri, Szilvia Kovács, Cintia Adácsi, Ida Miklós, Szabina Király, István Pócsi, and Tünde Pusztahelyi. 2025. "Unveiling the Perspective on Weissella confusa as a Promising Biocontrol Agent Against Fusaria" Microorganisms 13, no. 3: 666. https://doi.org/10.3390/microorganisms13030666
APA StyleKrishnan, S. V., Anaswara, P. A., Nampoothiri, K. M., Kovács, S., Adácsi, C., Miklós, I., Király, S., Pócsi, I., & Pusztahelyi, T. (2025). Unveiling the Perspective on Weissella confusa as a Promising Biocontrol Agent Against Fusaria. Microorganisms, 13(3), 666. https://doi.org/10.3390/microorganisms13030666

